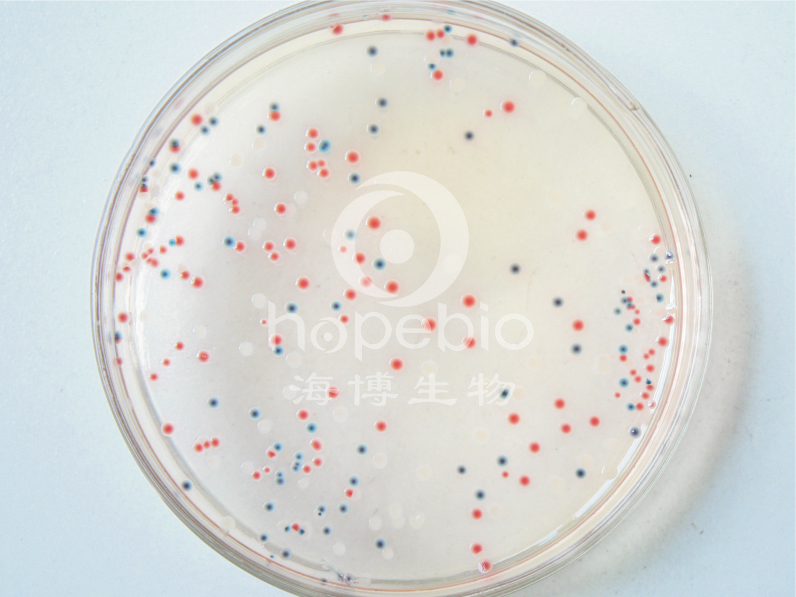

海博微信公众号
海博微信公众号
 海博天猫旗舰店
海博天猫旗舰店


 海博微信公众号
海博微信公众号
 海博天猫旗舰店
海博天猫旗舰店



多达600种微生物培养基配方、原理、用法、质量控制,涵盖所有常检细菌及其他细菌,涉及食品卫生检验、医药、水质、临床、化妆品等各个领域、为您提供最详尽的微生物培养基相关知识。



应用范围:大肠杆菌/大肠菌群显色培养基(第二代)是青岛海博生物公司再次改良的培养基,用于食品、水、牛奶、冰激凌和肉制品中大肠杆菌和大肠菌群的快速检测。大肠杆菌显蓝色至紫色,大肠菌群显红色,革兰氏阳性菌被抑制。
| 特殊营养物质 |
33.0 |
| 显色剂 |
0.3 |
| 琼脂 |
13.0 |
| pH 7.0±0.2 25℃ | |
此配方可以进行改良或增加营养成份以获得最佳的结果。
|
质控菌株 |
ATCC |
生长情况 |
菌落颜色 |
|
金黄色葡萄球菌 |
25923 |
-/+ |
无色 |
|
大肠杆菌 |
25922 |
+++ |
蓝色 |
|
沙门氏菌 |
14028 |
+++ |
无色 |
|
阴沟肠杆菌 |
23355 |
+++ |
粉红色 |
|
产气肠杆菌 |
35029 |
+++ |
粉红色 |
|
弗氏柠檬酸盐杆菌 |
43864 |
+++ |
粉红色 |
|
肺炎克雷伯氏菌 |
10031 |
+++ |
粉红色 |
大肠杆菌/大肠菌群显色培养基(第二代)相关产品配方:
大肠杆菌/大肠菌群显色培养基(第二代)相关产品配方:|
产品货号 |
查看配方 |
产品说明及用途 |
查看产品详情 |
|
HB5213
|
MUG培养基 |
用于药品和生物制品中大肠埃希氏菌的检测
|
|
|
HB0141
|
茜素-β-半乳糖苷琼脂 |
用于食品、饮料和饮用水中大肠菌群快速检测和计数(GB/T)
|
|
|
HB7001
|
大肠杆菌显色培养基 |
用于快速、准确检测大肠杆菌大肠杆菌培养24小时,大肠杆菌显蓝绿色
|
|
|
HB7002
|
大肠菌群显色培养基 |
用于快速、准确检测大肠菌群,培养24小时,大肠菌群显蓝绿色
|
|
|
HB7004
|
TBX培养基 |
用于快速、准确检测大肠杆菌,培养24小时,大肠杆菌显蓝绿色
|
|
|
HB7005
|
细菌总数显色培养基 |
用于快速、准确检测细菌总数,培养24小时,细菌显红色
|
|
|
HB7006
|
O157显色培养基 |
用于O157菌的显色培养,O157菌显亮红色、淡红色或红色
|
|
|
HB7008
|
李斯特氏菌显色培养基 |
用于李斯特氏菌的显色培养,单增李斯特氏菌显蓝色,外围有一不透明环
|
|
|
HB7009
|
金黄色葡萄球菌显色培养基 |
用于金黄色葡萄球菌的显色培养,金黄色葡萄球菌显蓝绿色。
|
|
|
HB7010
|
霉菌和酵母菌显色培养基 |
用于霉菌和酵母菌的显色培养
|



